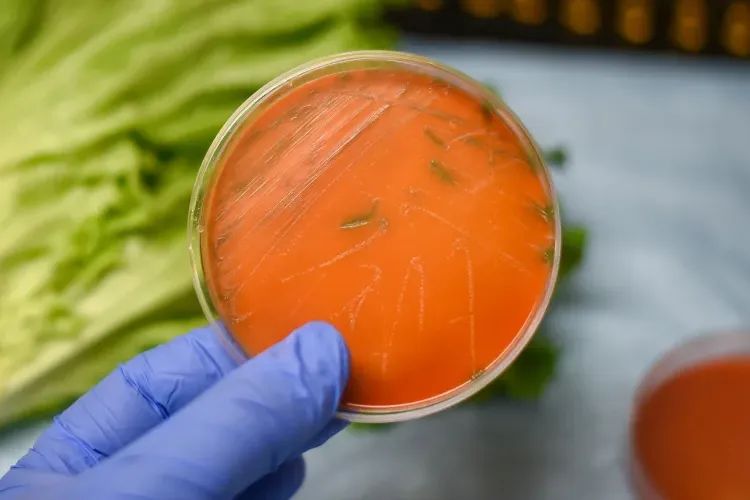

美国疾病控制与预防中心宣布,11个州爆发的致命李斯特菌与数十种乳制品有关,其中包括流行的超级碗小吃queso fresco和Cotija奶酪。能做些什么降低被感染风险呢?
李斯特菌是一种生命力顽强的细菌,它能够在冷藏条件下继续生长,即使是沙门氏菌和大肠杆菌也无法做到这一点。据CDC称,李斯特菌是美国食源性疾病导致死亡的第三大原因,每年导致约260人死亡。
美国食品和药物管理局表示,“即使采用足够的抗生素治疗,这种疾病的死亡率也很高,”高达20%至30%。免疫系统健康的成人和儿童可能只是患上轻微或不舒服的疾病,不需要竹原或服用抗生素,然而任何免疫力功能低下的人,例如老年人、器官移植患者、癌症或肾病患者、糖尿病患者或艾滋病患者,都可能患上重病甚至死亡。
孕妇感染李斯特菌的可能性大约是普通人的10倍,而且这种疾病是致命的,FDA表示,怀孕的西班牙裔人面临的风险更高,可能是因为吃了传统的软奶酪,如queso fresco和其他未经高温消毒的牛奶制成的食品。该机构表示,用生奶制成的食品含有李斯特菌的可能性高出50至160倍。

CDC表示,2014年6月至2023年12月期间,来自11个州的26个人感染了当前爆发的李斯特菌株,加利福尼亚州和德克萨斯州报告了两起与感染相关的死亡事件。最近对病人的采访和设施检查使疾病预防控制中心确定Rizo-Lopez Foods生产的queso fresco和Cotija奶酪是疾病的来源。
美国疾病控制和预防中心(CDC)称熟食肉和热狗是20世纪90年代李斯特菌爆发的常见来源,可能是因为很难清除熟食食品制备设备中每个角落和缝隙中的耐药细菌。并且其爆发与哈密瓜、芹菜、冰淇淋、菠菜等绿叶蔬菜、软奶酪和豆芽有关。
保持厨房清洁:定期用热水和液体肥皂清洁冰箱,分开准备肉类和蔬菜,并确保对食物准备区域进行消毒。
保持冰箱凉爽:由于李斯特菌很容易在低温下生长,因此请将冰箱温度保持在41华氏度(5摄氏度)或更低,冷冻室温度应为零华氏度(负18摄氏度)或更低。
生牛奶:CDC表示,食用生牛奶制成的食品是感染李斯特菌和其他有害细菌的“最危险”方式之一。

软奶酪:如果您怀孕或处于高风险状态,请勿食用软奶酪,例如queso fresco、queso blanco、panela(queso panela)、布里奶酪、卡芒贝尔奶酪、蓝纹奶酪或羊乳酪,除非标签上注明用巴氏杀菌牛奶制成。然而该机构表示,一些软奶酪在奶酪制作过程中收到了污染。
豆芽:CDC表示,不能仅冲洗苜蓿、三叶草、萝卜、绿豆或任何类型豆芽上的细菌。高风险人群不应该吃生的甚至稍微煮熟的豆芽。一定要先彻底加热豆芽,外出就餐时,请务必要求食物中不要添加生的喷嘴。
绿叶蔬菜:某些绿叶生菜,如羽衣甘蓝、菠菜、生菜等,生长在离地面较低的地方,更容易被土壤中的李斯特菌污染,CDC表示,为了安全起见,请清洗任何蔬菜,参考如下步骤:
处理绿叶蔬菜前和后用肥皂水清洗20秒。
不要将蔬菜浸泡在水槽中,这会让一片叶子上的细菌传播到所有叶子上。
除去任何撕裂、擦伤或外层的叶子。
在流水下轻轻擦洗每片叶子,然后用干净的布擦干叶子。

瓜类:瓜类是李斯特菌感染的另一个来源。CDC表示,切开的瓜应立即食用,未冷藏的瓜类应在四个小时或更长时间内扔掉。将切好的甜瓜在41华氏度(5摄氏度)或更低的温度下冷藏不超过7天。
熟食肉类和热狗:如果您怀孕或处于高风险状态,请勿食用冷盘,例如博洛尼亚香肠、热狗、午餐肉、发酵或干香肠以及任何其他熟食肉类,除非他们被加热到热气腾腾(165度)。不要食用熟食店、肉类柜台或商店冷藏区的冷藏肉酱,打开前不需要冷藏的肉酱,例如罐头或密封袋中的产品是更安全的,这些食物开封后要冷藏。任何在家吃这些食物的人都应该小心,不要让热狗或午餐肉包装中的汁液沾到其他食物或盘子、器皿上。接触任何类型的热狗或者熟食肉类后,一定要仔细洗手。工厂密封的未开封热狗和熟食肉类在冰箱中存放两周后需扔掉,三到五天后扔掉切片。
冷熏鱼:CDC表示如果您处于高风险状态,请勿食用冷熏鱼,除非他是罐装、保质期稳定、或者是放在煮熟菜肴中的。耐储存的食品如鱼类罐头,不会增加感染李斯特菌的风险。CDC表示并非所有罐头食品都能稳定保存。



